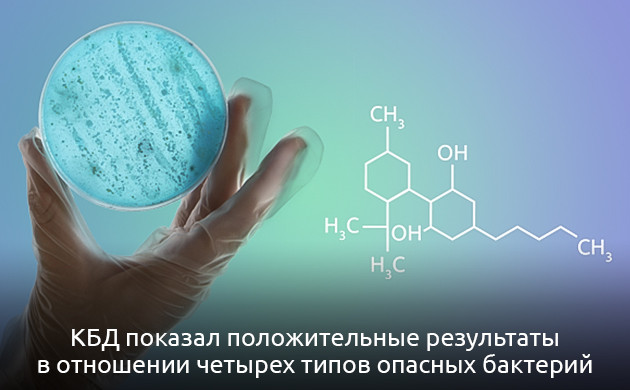
Эффективность КБД против грамположительных бактерий

Самые известные и содержащиеся в наибольших количествах соединения каннабиса – это тетрагидроканнабинол (ТГК) и каннабидиол (КБД). Если первое вещество отвечает за психоактивный эффект, то КБД больше применяется в медицинских целях.
1. КБД против бактерий |
В последние годы каннабидиол востребован в индустрии велнеса и здорового образа жизни. Он используется в качестве альтернативного способа лечения различных расстройств и недугов. Начиная с 2018 года, исследовательская работа направлена на изучение антимикробных свойств КБД.
КБД против бактерий
Благодаря новым данным, полученным в ходе последних исследований, выяснилось, что КБД в действительности достаточно неплохо борется даже с теми бактериями, которым не страшны традиционные антибиотики. Теоретически новый способ противодействия бактериям может спасти множество жизней, вещество достойно справляется с грамположительными бактериями, против которых обычные антибиотики не эффективны. Согласно результатам исследований, проводившихся в 2021 году, небольшие дозы каннабидиола могут бороться с устойчивыми к антибиотикам бактериями, вызывающими развитие кишечных инфекций, пневмонии и менингита.
В отношении грамотрицательных бактерий КБД продемонстрировал не такие впечатляющие результаты, однако это вполне предсказуемо, учитывая их специфику. Но наибольшим сюрпризом для ученых стал тот факт, что КБД показал положительные результаты в отношении четырех типов устойчивых и опасных бактерий, провоцирующих развитие гонореи, передаваемой половым путем, менингита, бронхита и легионеллеза. Таким образом, каннабидиол подтвердил свой потенциал в качестве эффективного антимикробного средства, что повлекло ряд дальнейших исследований, в ходе которых была изучена роль КБД в борьбе с бактериями сальмонеллы.
Многие устойчивые бактерии сопротивляются проникновению антибиотических препаратов в свои клетки. Подобные защитные свойства микробов не помеха для КБД, которому не нужно проникать в клетку бактерии для того, чтобы убить ее. В отличие от традиционных антибиотиков КБД наносит удар по мембранам бактерий и разрушает клетки микробов, как микроскопические воздушные шарики. Такой характер эффекта свойственен для некоторых распространенных антибиотиков, в частности для пенициллина, также атакующего мембраны бактерий. Новые исследования направлены на определение дальнейшего перечня вредных микроорганизмов, с которыми может эффективно бороться каннабидиол.
Востребованность нового лечения

По данным Центра по контролю и профилактике заболеваний США, почти 3 миллиона человек ежегодно переносят заболевания, вызванные бактериями с высокой устойчивостью к антибиотическим препаратам. Из них более 35 тысяч умирает в результате таких болезней каждый год. В случае применения КБД в качестве лекарственного вещества, к которому у ряда бактерий не наблюдается устойчивости, новый метод борьбы с заболеваниями способен значительно сократить эти печальные показатели.
Перспективное направление исследований

Несмотря на обнадеживающие лабораторные данные, пока что рано говорить о быстром внедрении препаратов на основе КБД в качестве общедоступного средства для борьбы с бактериями, поскольку у этого соединения есть один существенный недостаток, не позволяющий ему стать чудесным лечебным средством. Когда КБД попадает в организм, молекулы вещества прикрепляются к белкам плазмы, циркулирующим в кровеносной системе, в результате чего лишь 10-14 % свободно перемещающихся молекул каннабидиола могут бороться с бактериями. В перспективе дальнейшая научная работа позволит в полной мере воспользоваться преимуществами КБД, чтобы эффективно доставлять молекулы вещества в очаг поражения бактериями. Либо будет создан синтетический аналог соединения, который не станет соединяться с белком плазмы, взаимодействуя только с клетками микробов.
Автоцветущие сорта конопли с высоким содержанием КБД
В ассортименте магазина «Семяныч» есть множество сортов конопли c высоким содержанием КБД. Вырастить их смогут даже начинающие гроверы. Предлагаем вашему вниманию небольшую подборку автоцветущих сортов каннабиса с высоким содержанием каннабидиола.
- Автоцветущие
- 17 %
- Целебный и успокаивающий
- Индор: 500 - 600 г/м²
Сорт конопли CBD Lemon Auto представляет собой качественный и надежный посадочный материал из коллекции испанского сидбанка Herbies Seeds, подходящий для садоводов любого уровня мастерства и направленности. Гены прославленного Lemon Kush пришлись по душе как коммерческим гроверам, которые стремятся получить смолистый урожай в больших количествах, так и новичкам, находящимся в поисках послушного растения для простого грова. Кусты сорта развиваются быстро и стремительно, успевая пройти весь свой жизненный цикл за 70-75 дней. Они устойчивы к дождям, жаре и резким перепадам температуры, а также не боятся засухи. И в открытом, и в закрытом грунте за ними не потребуется особый уход, а итоговый результат не разочарует. Дегустация собранного урожая сопровождается ярким ароматом спелых цитрусовых фруктов и таким же вкусом с легкими пряными нотками. Воздействие дополняет все это своим седативным эффектом без упора в психоактивность. Пользователь сохраняет связь с реальностью, спокойно выполняет повседневные дела и ощущает улучшение самочувствия благодаря лечебным свойствам каннабиса.
- Автоцветущие
- 4 - 6 %
- Индор: 400 - 500 г/м² Аутдор: 50 - 150 г/куст
Сорт конопли Auto CBD-Victory – первоклассная генетика из коллекции именитого голландского сидбанка Dutch Passion, полученная в результате тщательного отбора родительских генетик и профессиональной селекции. Производитель сумел добиться высокого содержания не только КБД, но и КБДВ, сократив уровень ТГК до минимума и повлияв тем самым на качество эффекта. Дегустатора будет ждать не яркое путешествие по астральному измерению, а легкое расслабление, снимающее напряжение, стресс и головную боль. Скрасит приятное времяпрепровождение изысканный аромат сосны и кисло-сладкий фруктовый вкус с травяными мотивами. По выращиванию быстрорастущего автоцвета можно сказать многое, начиная с короткого жизненного цикла длиной в 10 недель и заканчивая неприхотливостью растишки. Она спокойно обходится минимальной заботой, принося при этом щедрое количество смолистых соцветий при любом способе культивации. Отличный выбор как для бывалого гровера, так и для новичка.
- Автоцветущие
- 7 %
- Терапевтический, расслабляющий
- Индор: 450 - 550 г/м² Аутдор: 50 - 170 г/куст
Сорт конопли CBD Green Crack Auto – представитель генетик с высоким медицинским потенциалом из коллекции сидбанка Семяныч. Этот автоцвет был разработан на базе генетики Green Crack и неизвестного растения с приличным уровнем содержания КБД. Все основные достоинства родителей благополучно перекочевали в их преемника вместе с быстрым ростом и прекрасным лечебным воздействием, снимающим стресс и усталость за считанные минуты после использования готового продукта. Культивация сорта протекает стабильно как в помещении, так и на улице. Кусты радуют нетребовательным характером, хорошей реакцией на легкие тренировки и крепким иммунитетом, защищающим от большинства угроз внешней среды. Их средняя высота составляет 80-110 см, а жизненный цикл длится от 9 до 10 недель. Сбор урожая даст садоводу порядка 450-550 грамм шишек, пропитанных ароматом цитрусовых фруктов, с одного квадратного метра в индоре и 50-170 грамм с одного куста в аутдоре.
- Автоцветущие
- 6 %
- Обезболивание и релакс
- Индор: 50 г/куст Аутдор: 50 г/куст
Сорт конопли DC Cure 1:1 Auto CBD от канадского сидбанка Doctor's Choice позволяет с успехом совмещать приятное с полезным. При дегустации его готового продукта можно не только наполниться бодростью и вдохновением, но еще и избавиться от симптомов большого числа недугов, например, таких как стресс или мигрень. Его активно применяют как в рекреационных, так и в терапевтических целях, решая все свои проблемы. Вкус и аромат тоже принимают в этом участие, радуя свежими нотками прохладной земли и сладких цитрусовых фруктов. Выращивание сорта не отнимает много времени, ведь весь путь от семени до харвеста займет порядка 60-70 дней. Компактные кусты высотой в 75-110 сантиметров, несмотря на свои габариты, хорошо защищены от внешних угроз, включая непогоду и резкие перепады температуры. Также они охотно отвечают на низкострессовые методы тренировок, такие как LST-подгиб и ScrOG. Итоговая урожайность при высадке семян в открытом грунте составляет около 50 грамм спелых шишек, собранных с одного куста.
- Автоцветущие
- 7 %
- Позитивный взгляд на мир
- Индор: 450 - 550 г/м² Аутдор: 50 - 170 г/куст
Сорт конопли CBD Auto 1:1 в очередной раз доказал, что специалисты сидбанка FastBuds знают толк в качественном каннабисе и способны создавать первоклассные растения в самых разных категориях. На этот раз у них получился превосходный терапевтический гибрид, способный за короткий срок избавить пользователя от нервного напряжения, хронических болей, глаукомы или симптомов рассеянного склероза. Также готовый продукт сорта удивляет вкусовые рецепторы прекрасными нотками спелого манго и острого перца. Еще во время выращивания можно будет понять, что это превосходное творение настоящих профессионалов, которые сделали все для облегчения ухода за растишкой. Она нетребовательна к навыкам садовода, хорошо отвечает на тренировки и не боится большинства распространенных угроз окружающей среды. При этом она по-прежнему приносит достойный урожай отменного качества, целиком и полностью пропитанный густой смолой, прилипающей к пальцам.
*Вся представленная информация носит исключительно ознакомительный характер и не является руководством или призывом к действию.
**Напоминаем, что использование семян марихуаны в качестве посевного материала (выращивание конопли с целью получения растения) запрещено УК Российской Федерации. Подробнее с законом Вы можете ознакомиться здесь.

Все комментарии проходят модерацию. Правила для публикаций:
Общие вопросы, не относящиеся к статье, также будут удалены.